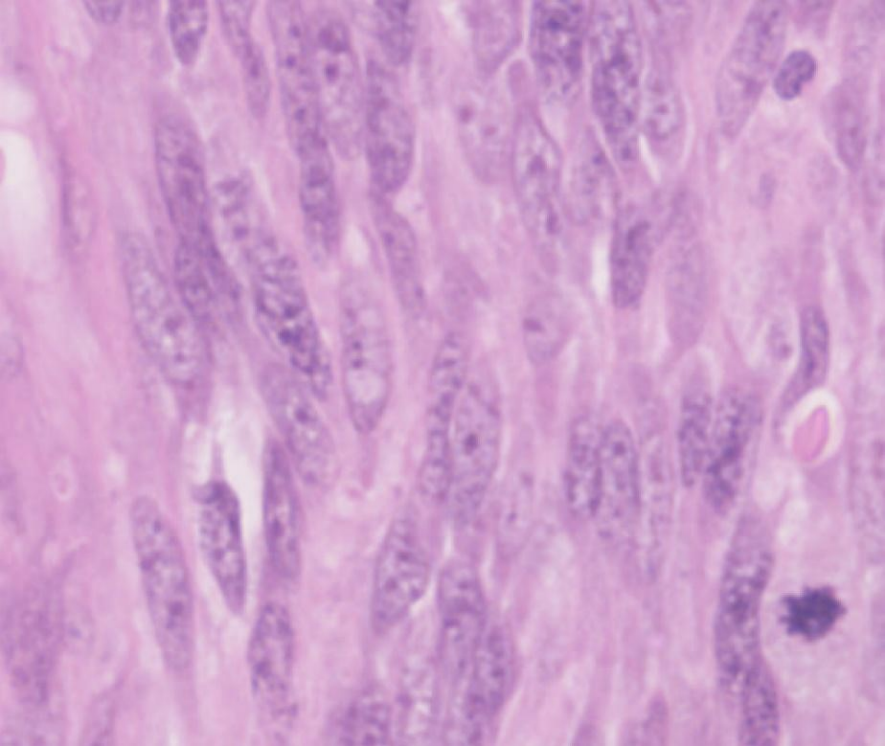
<p>A high power histology image of a leiomyosarcoma- List the key findings in a leiomyosarcoma that are absent from a leiomyoma.</p>

Practical 21: Neoplasia 1
1/44
There's no tags or description
Looks like no tags are added yet.
Name | Mastery | Learn | Test | Matching | Spaced | Call with Kai |
|---|
No analytics yet
Send a link to your students to track their progress
45 Terms
May expand into surrounding tissue but does not invade into it
Benign
Can evade programmed cell death by apoptosis.
Benign/ Malignant
Invades into adjacent tissue
Malignant
Can spread/metastasize around the body.
Malignant
Benign epithelial neoplasms
-oma
Malignant epithelial neoplasm
-carcinoma
Benign tumour of glandular epithelium
Adenoma
Benign tumour of squamous epithelium
Papilloma
Malignant tumour of glandular epithelium
Adenocarcinoma
Malignant tumour of squamous epithelium
Squamous cell carcinoma
Connective tissue (mesenchymal) benign neoplasms
-oma
Connective tissue (mesenchymal) malignant neoplasms
-sarcoma
Benign tumour of fat
Lipoma
Malignant tumour of bone
Osteosarcoma
Benign tumour of cartilage
Chondroma
Malignant tumour of skeletal muscle
Rhabdomyosarcoma
Benign tumour of smooth muscle
Leiomyoma
What is the most common malignant tumour in humans?
carcinomas
What is the most common malignant tumour in cats?
sarcomas-often aggressive, rapidly growing neoplasms and are highly invasive.
Which visible clinical feature in this sarcoma of a cat might have alerted the vet to the fact that it was a malignant tumour?
This tumour has invaded into adjacent tissues and even through the skin.

The Multistage Development of Neoplasia

adenoma
An adenoma is a pre-invasive tumour of glandular epithelium.
Adenomas do not invade into the muscularis mucosae, nor do they metastasise.
Colonic Adenomatous Polyp
Excessive, unregulated proliferation of the glandular epithelium has given rise to a polypoid structure, composed of branching, tubular glands on a stalk of normal mucosa.
The stalk is formed as peristalsis tends to pull the polyp along the gut, dragging out the normal wall.
The cells of the adenoma will have lost some differentiated features of the normal colon. They will be taller, more crowded and contain less mucin.
The nuclei will still be seen towards the base of the cells, but show variation in shape, nuclear size, chromatin staining pattern (pleomorphism) and stain more darkly than normal (hyperchromasia). A small number of mitotic figures will be seen.
These features collectively are termed dysplasia.

What is this?
anatomy of a benign polypoid adenoma

Development of Carcinoma Within an Adenomatous Polyp
Foci of adenocarcinoma can develop in a proportion of benign adenomas.
Short stalk of normal mucosa inferiorly.
There is a focus of invasive malignant cells at the top of the stalk which has arisen from a cell within the adenoma.
The epithelial cells are invading down into the stalk (having invaded through the basement membrane and through the muscularis mucosae).

benign polypoid adenoma with a distinct area of carcinoma

Muscularis Mucosae Within an Adenomatous Polyp
For most carcinomas, invasion through the basement membrane is the technical definition of malignancy. An area of invasive adenocarcinoma 8
This is hard to see in colorectal cancers, so, pragmatically, invasion of the muscularis mucosae is taken instead as the defining visual feature of malignancy

Advanced Adenocarcinoma of the Colon
The malignant cells have invaded through the muscularis mucosae and into the underlying thick muscle band (known as the muscularis propria).
Islands of cells form ragged glandular structures, growing in between the muscle fibres.
Cell show: pleomorphism (cells have very variable appearances).; increased nuclear: cytoplasmic ratio. ; less mucin. ; frequent mitotic figures. ; frequent apoptotic bodies.
The stroma they invade into becomes fibrotic (desmoplastic).
malignant cells may then spread (metastasize) to other sites/ organs: via the blood ; via lymphatics and ; across the peritoneal cavity (transcoelomic spread), if the carcinoma invades through the muscularis propria.

Normal glandular epithelium
The adenocarcinoma has not breached the muscularis mucosae


What does this show?
Deeper in the intestinal wall, very irregular glands (G) have induced a very fibrotic (desmoplastic) stromal response around themselves. Some remnants of invaded parts of the muscularis propria (MP) can be seen (outlined in blue).

What does this show?
At the deep edge of the tumour, it is poorly differentiated, barely forming glands (a few residual ones are denoted as G) and is invading the muscularis propria (MP).
What is the clinical significance of the occurrence of adenocarcinoma within an adenoma?
The adenoma is the precursor, part of which develops into the invasive adenocarcinoma. Most adenomas do not progress to adenocarcinomas; this only occurs in a small proportion of adenomas after many years. Those that do progress to adenocarcinoma however have invasive malignant potential and may eventually metastasise.
What do you understand by the term moderately differentiated adenocarcinoma?
Moderately differentiated describes the “grade” of the cancer in terms of how well or poorly it resembles the original parent tissue. High-grade or poorly-differentiated cancers often show little resemblance to the parent tissue, in contrast to well-differentiated or low grade cancers, which closely resemble the original tissue.
Cancers that fall between the two groups are termed moderately-differentiated. Those that are so poorly differentiated that their tissue of origin is unclear are termed anaplastic.
Which features in the adenocarcinoma section would help you in predicting the behaviour of this neoplasm?
Behaviour of neoplasms can predicted by:
• Grade: How well or poorly differentiated the tissue is.
• Stage: Whether the neoplasm has spread, either locally (direct invasion) or to other parts of the body (metastasis).

Describe the architecture of the histological section, comment on the cytology, identify the pathological process and give a diagnosis.
Architecture: This section of large intestine shows gland forming malignant cells that are infiltrating through the full thickness of the mucosa, muscularis mucosae, submucosa and focally into the muscularis propria of the colon.
Cytology: The cells are pleomorphic, have an increased nuclear: cytoplasmic ratio and are making much less mucin than their normal counterparts. They are undergoing frequent mitosis and apoptosis. The adjacent stroma is desmoplastic.
Process: Malignant neoplasia
Diagnosis: Adenocarcinoma of the colon
Metastasis to the Liver
generally the spread or metastasis of cancer to other organs that causes illness and death. For example, spread to the liver, lung, brain or bone can prevent them from performing their normal functions.


What is this?

Via what routes might a colonic adenocarcinoma have spread to the liver?
Haematogenous, lymphatic, trans-coelomic, locally invasive spread.

Metastasis to a Lymph Node - Where might this tumour have come from and by what route might it have spread?
Breast; lymphatic spread
• Why do metastatic deposits sometimes show evidence of necrosis?
The fast growth of the tumour outstrips the growth of the vascular supply leading to ischaemic areas which undergo necrosis.
Tumours of the Mesenchyme
Criteria for distinguishing malignant from benign mesenchymal tumours are different from those for epithelial tumours and this distinction can be much more difficult.
leiomyoma, a benign smooth muscle tumour of the uterus, and its malignant counterpart, a leiomyosarcoma.
Unlike colorectal adenocarcinoma, leiomyosarcoma tends to occur de novo and not from a benign neoplasm. It is very rare that a leiomyosarcoma arises from a pre-existing leiomyoma.
Leiomyomas of the uterus are very common benign tumours often referred to as fibroids.
The leiomyomas are distinct, round, circumscribed bodies in the uterine wall with a whorled cut surface.
Leiomyoma
A Benign Smooth Muscle Tumour
The leiomyoma is a round ball of cells in a swirling pattern.
tumour remains a distinct mass of cells, separated from the surrounding normal tissue

high power histology of benign smooth muscle tumour cells
leiomyomas show little nuclear pleomorphism and almost no mitotic figures.
Leiomyosarcoma
A Malignant Smooth Muscle Tumour
Uterine leiomyosarcomas are very uncommon
much more difficult than in a benign leiomyoma to work out which are tumour cells and which are normal.
malignant cells invade into the surrounding smooth muscle of the myometrial wall and tongues of malignant cells spread between strands of normal muscle.
The leiomyosarcoma shows more nuclear enlargement and pleomorphism than the leiomyoma
Mitotic figures are frequent in this leiomyosarcoma, while it is unlikely you will find mitoses in the leiomyoma.
A high power histology image of a leiomyosarcoma- List the key findings in a leiomyosarcoma that are absent from a leiomyoma.
Invasion into surrounding tissue
lack of clear margins of the tumour
mitotic figures, apoptotic bodies
nuclear pleomorphism
nuclear hyperchromasia
visible nucleoli
crowding of the cells.